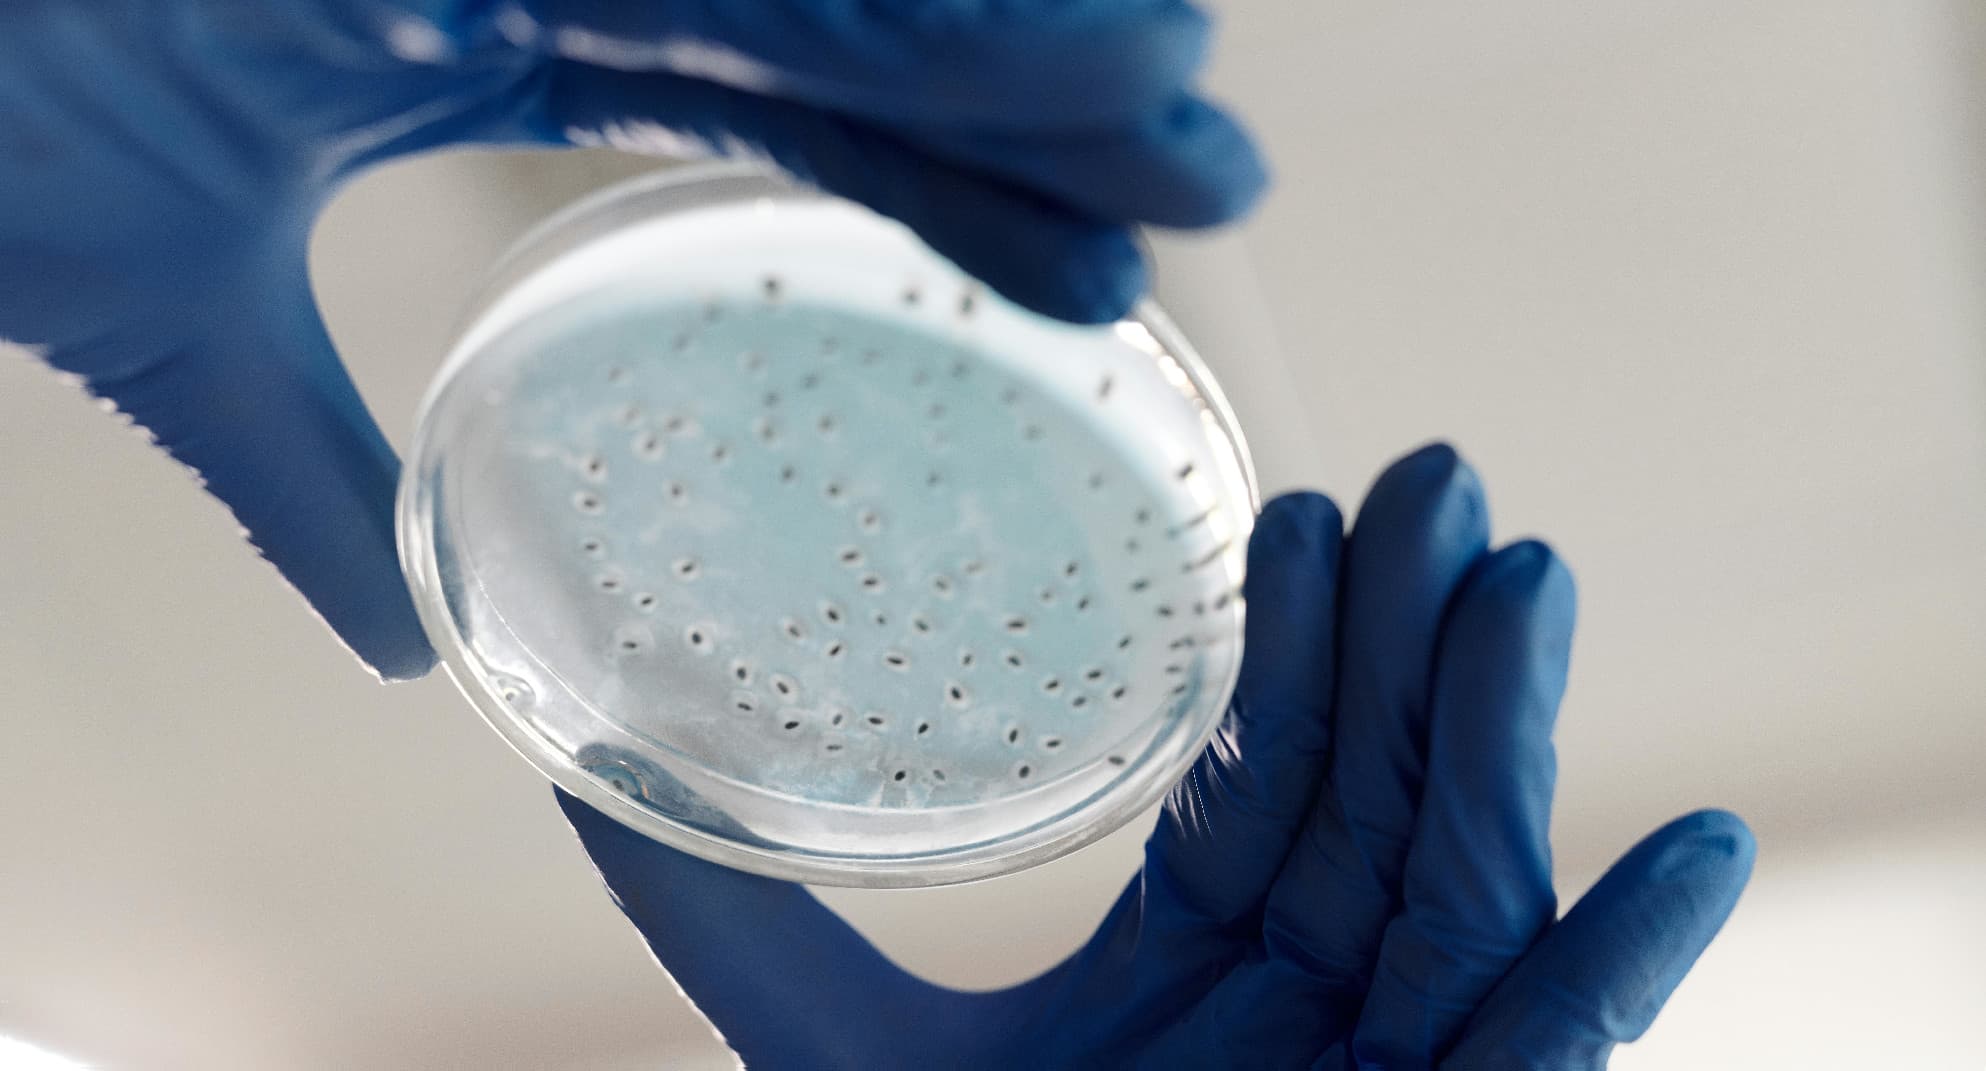
Slide 2

Exploring the future of biology through computation.
Join a growing community of students working on real problems
in synthetic biology, neuroscience, and machine learning.
Tackle real-world problems in biology and AI through student-led competitions like the NeuroBio Challenge. Gain experience, build your portfolio, and connect with a community of future researchers.
We provide tools, mentorship, and guidance to help students launch independent bio-AI projects, from idea to implementation. Whether you're experimenting, prototyping, or publishing, we're here to back you.
We support students with beginner-friendly tutorials, datasets, and mentorship to help them build original bio-AI projects and explore research ideas — no lab coat required.
The NeuroBio Challenge is a national, student-led competition where high schoolers explore real-world problems at the intersection of biology and artificial intelligence. Whether you're designing a machine learning model to analyze genetic data or prototyping an AI tool for neuroscience, this challenge encourages innovation, critical thinking, and interdisciplinary research — no prior experience required.